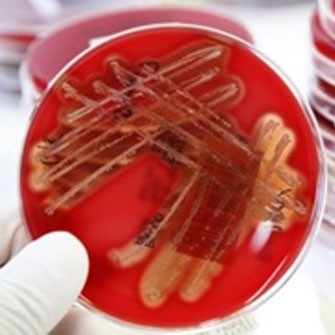
acido-laurico-protetto.jpg

DRAX S
DRAX S
- Acido laurico protetto per l’equilibrio della flora batterica intestinale
La salubrità intestinale dipende dall’interazione tra dieta, integrità della mucosa e equilibrio della flora intestinale : un microbiota intestinale stabile coadiuva digestione e assorbimento dei nutrienti, limita le malattie intestinali e promuove uno stato immunitaria efficace.
Batteri Gram+, come streptococchi, stafilococchi e clostridi provocano danni considerevoli alla salute degli animali e notevoli perdite finanziarie per l'allevatore.
Streptococcus suis viene trasmesso per contatto diretto o diffuso per contatto indiretto tramite le goccioline disperse nell'aria con la respirazione.
I suini sani possono trasportare il microrganismo per diversi mesi nelle tonsille e le scrofe possono agire da portatrici sane.
La scrofa trasmette gli anticorpi al suinetto attraverso il colostro e per questo motivo la malattia è poco comune negli animali allattanti.
La malattia è molto comune nel primo periodo dopo lo svezzamento e spesso compare 2-3 settimane dopo e prosegue fino a circa 16 settimane di età.
Nello svezzamento quasi il 100% dei suini diventa portatore entro tre settimane.
Danni economici da streptococco
Alta morbilita’ | 10-50%
Alta mortalita’ | 5-20%
Minor incremento medio giornaliero | 20/40 g/die
Giorni di produzione persi | +8/15 gg
Riduzione consumo alimentare | -20/50%
Peggiore conversione alimentare | +20/30%
Aumento costi medicazioni | +1-5 €/suino
Aumento costi manodopera/possibile contagio manodopera
Gram



La parete cellulare dei batteri Gram+ è costituita per il 50-90% da peptidoglicani, mentre i Gram- hanno una membrana aggiuntiva di natura polisaccaridica e una sottile membrana di peptidoglicani .
Tra tutti gli acidi grassi saturi a media catena , l'acido laurico è quello con la più forte attività antimicrobica contro i batteri gram-positivi e contro alcuni virus e funghi.
L'acido laurico è in grado in grado di interporsi nella parete cellulare costituita da peptidoglicani provocando delle vere e proprie rotture della stessa : una volta all'interno della cellula, può inoltre interferire con i processi di trasduzione e trascrizione genica batterica.
Considerazioni economiche
Nella fase post svezzamento DRAX S ha dimostrato di poter egregiamente sostituire o diminuire il dosaggio e/o il tempo di utilizzo degli antibiotici comunemente utilizzati per prevenire la Strptococcosi.
Rispetto al gruppo controllo ( no antibiotico , no additivi ) DRAX S ha garantito un ritorno economico del 20% in più del valore di mercato dei suinetti.
Quando utilizzare DRAX S

- Per prevenire fenomeni di diarrea post-svezzamento
- Per diminuire l’incidenza delle problematiche da Streptococco
- Durante la fase di passaggio tra mangimi di qualità diversa
- In situazione di stress da caldo o restrizione alimentare
- Per migliorare lo stato sanitario generale
Compila il modulo per richiedere le informazioni che ti servono, risponderemo il prima posibile in modo esaustivo